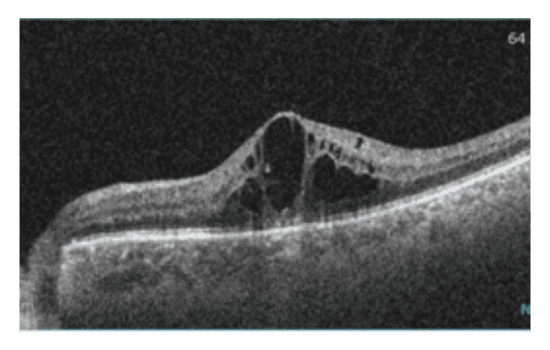
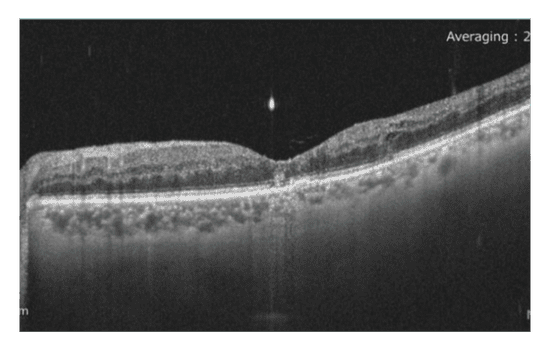

Case study
ERG to Replace FA for CRVO Treatment Decision
by Dr. Miho Nozaki, Nagoya City University East Medical Center, Japan
An 87-year-old male patient presented for a routine check-up without any visual issues. His medical history included pulmonay hypertension cardiac amyloidosis and a brain stroke six months prior.

Upon examination, significant central edema and central retinal vein occlusion (CRVO) was observed in his left eye via fundus imaging and OCT. Despite these findings, visual acuity in the left eye was maintained at 20/20. In the absence of symptoms, the patient was monitored closely. Since he was less than six months post-stroke, anti-VEGF injections were put on hold.
Three months later, the patient returned with unchanged retinal edema volume, but a deteriorated retinal appearance and slightly reduced visual acuity of 20/25. There was the concern that the CRVO had progressed to an ischemic state.
|
|
|
Because of the patient’s cardiac amyloidosis, conducting fluorescein angiography posed a risk. Consequently, an ERG using the RETeval®, Flicker 16 Td·s
protocol was performed to gather essential information while minimizing potential complications associated with contrast agents.
Why was the ERG test performed?
The goal was to understand the nature of the patient’s CRVO and determine ischemic risks in a safe manner. The results of the ERG were critical for developing his treatment plan.
What were the ERG findings?
The ERG results showed an implicit time of 35.5 ms in the waveform. Miyata et al. found a difference of 4 ms between the healthy and the affected eye to be indicative for the ischemic type of CRVO1. Kijeka et al. found a high risk of progression to neovascularization for patients with an implicit time of >35 ms. This patient had an implicit time difference of 1 ms between his eyes, but a relatively big difference in amplitude and implicit time of >35 ms, suggesting a higher risk of progression2.
| Healthy eye OD | Affected eye OS |
|---|---|
![]() |
![]() |
Considering the heightened risk of progression and a potential ischemic type of CRVO, treatment options were discussed with the patient. After a thorough explanation of potential risks and side effects, the patient opted for anti-VEGF injections. Additionally, a panretinal photocoagulation (PRP) procedure was performed following an initial loading phase of injections. This comprehensive approach aimed to address the underlying ischemic changes and mitigate the risk of further deterioration.
How did ERG influence the patient’s care?
Following administration of a third anti-VEGF injection, the patient’s BCVA improved to 20/20. Additionally, retinal appearance showed signs of improvement, and the previously observed edema had resolved. To further assess retinal function, a repeat ERG was conducted, after one month and on the day of the first PRP session, revealing promising results. The implicit time decreased from 35.5 to 33.9 ms, indicating a positive response to treatment, albeit with residual ischemia. Moreover, there was a 50% recovery in amplitude (from 11.7 µV to 20.8 µV), suggesting enhanced retinal functioning after three injections and directly before laser treatment.
|
|
|
Conclusion
In cases where standard of care diagnostic options, such as FA or ICGA, are not available or pose additional risks, the RETeval may serve as a valuable alternative for assessing retinal conditions. This non-invasive test aids in differentiating the nature of CRVO, particularly when assessing ischemic changes that dictate treatment plans. Incorporating ERG into clinical practice enables thorough evaluation and tailored management strategies, especially in complex cases where conventional approaches may be limited.
| One month after first injection | After third injection on the day of first PRP laser treatment |
|---|---|
![]() |
![]() |
Dr. Miho Nozaki
Nagoya City University East Medical Center, Japan
Dr. Miho Nozaki graduated from Nagoya City University School of Medicine and furthered her studies at the University of Kentucky, USA, where she worked on basic research in the Laboratory of Ocular Angiogenesis. After returning to Japan, Dr. Nozaki became an associate professor at Nagoya City University School of Medicine, later becoming a professor at the Nagoya City University East Medical Center in September 2022. Her main research interests revolve around diabetic retinopathy, diabetic macular edema, fundus imaging, and development of new retinal laser techniques.